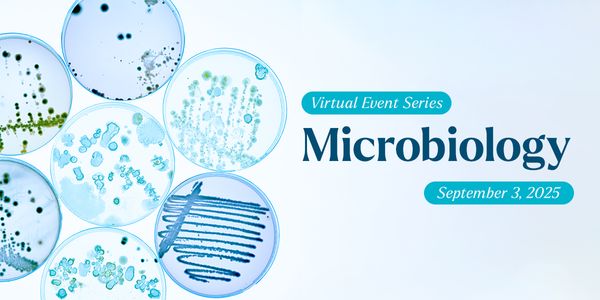
Microbiology Virtual Event Series 2025

Virtual Event Series
Table of Contents
Facts & Figures
Users
5 Million
Average Website Sessions
16 Minutes
25 Seconds
Average Webinar Sessions
31 Minutes
Average Virtual Event Sessions
3.55 Hours
Average Custom Virtual Event Sessions
3.02Hours
Average Hybrid Virtual Event Sessions
2.83 Hours
User Sessions
221K Monthly
2.65 Million Annually
Page Views
1.66 Million Monthly
20 Million Annually
Social Media Followers
2.53 Million+
Opted-In Newsletter Subscribers
697K+*
* We have recently optimized our database by archiving users who haven’t engaged with our campaigns in the past 90 days. As a result, we now have a highly focused, targeted database of engaged and active users.

User Location
North America: 51%
Asia: 20%
Europe: 19%
South/Central America: 4%
Oceania: 5%
Africa: 1%

User Institution Type
Academia: (University/College) 31% (1.7M)
Hospital/Medical Center: 24% (1.35M)
Commercial/Industry:
(Biotech/Pharma/Life Science Company): 22% (1.2M)
Private: (CRO, CMO, Research Institute)15% (850K)
Government: 6% (330K)
Other: 2% (120K)

Job Titles
- Clinical Laboratory Scientist/Medical Laboratory Technician/Clinician 7% (381K registrants)
- Consultant
2% (108K registrants) - Core Facility Manager
3% (156K registrants) - Education Specialist 10% (541K registrants)
- Engineer 4% (212K registrants)
- Executive Management 4% (217K registrants)
- Lab Management 12% (623K registrants)
- Nurse 2% (109K registrants)
- Physician/Doctor/Medical Expert 9% (488K registrants)
- Principal Investigator/Post Doc 4% (229K registrants)
- Purchasing/Procurement 2% (99K registrants)
- Research Scientist/Researcher/Scientist 24% (1.3M registrants)
- Student 12% (685K registrants)
- Other 7% (384K registrants)







Content Categories Trending Articles / Webinars / Virtual Events / Users
Health & Medicine: 12,689 / 5,932 / 440 / 852,139
Cell & Molecular Biology: 5,476 / 1,086 / 120 / 475,432
Technology: 5,249 / 530 / 80 / 450,139
Genetics & Genomics: 3,782 / 695 / 72 / 295,185
Microbiology: 3,766 / 695 / 72 / 295,185
Neuroscience: 4,451 / 516 / 49 / 313,447
Plants & Animals: 4,196 / 177 / 18 / 343,134
Earth & The Environment: 4,664 / 86 / 18 / 231,304
Cancer: 3,139 / 847 / 99 / 548,219
Clinical & Molecular DX: 3,440 / 843 / 131 / 357,142
Immunology: 3,004 / 933 / 99 / 264,537
Chemistry & Physics: 3,955 / 177 / 49 / 432,404
Drug Discovery & Development: 3,139 / 685 / 100 / 352,301
Space & Astronomy: 2,906 / 11 / 1 / 151,398 / 180,353
Cardiology: 2,179 / 167 / 36 / 283,459
Cannabis Sciences: 1,570 / 213 / 26 / 195,556
Virtual Event Series Overview
Bringing the scientific world together online. Labroots is the world’s largest producer of virtual events focused on the life sciences and clinical diagnostics community, exclusively online.
Virtual event features include:
- Free CE Credits (accredited by P.A.C.E.)
- Engaging networking opportunities with peers and professionals.
- Live or on-demand webinars delivered by industry experts.
- Educational posters and a live Poster Discussion with the authors.
- A virtual exhibit hall with companies showcasing advancements in life sciences and medical technologies.
- Speed networking sessions.
- No Cost and No Travel!
- Virtual Event & Webcasting Demo.
In partnership with:


NEW Speed Networking
Transform attendee engagement with speed networking at your next virtual or hybrid event.
*Request a demo to talk about your next event and how to incorporate speed networking.
Event Schedules
(Download 2025 Virtual Event Schedule)
Drug Discovery & Development Virtual Event Series 2025
Event Date: February 19, 2025
Neuroscience Virtual Event Series 2025
Event Date: March 5, 2025
Laboratory Automation Virtual Event Series 2025
Event Date: March 19, 2025
Bioprocessing Virtual Event Series 2025
Event Date: April 2, 2025
Cannabis Sciences Virtual Event Series 2025
Event Date: April 16, 2025
Immuno-Oncology Virtual Event Series 2025
Event Date: April 30, 2025
Precision Medicine: Genomics, Genetics & Molecular Diagnostics Virtual Event Series 2025
Event Date: May 14, 2025
Microbiology Virtual Event Series 2025
Event Date: September 3, 2025
Cell Biology Virtual Event Series 2025
Event Date: September 17, 2025
Cancer Research & Oncology Virtual Event Series 2025
Event Date: October 1, 2025
Cell & Gene Therapy Virtual Event Series 2025
Event Date: October 15, 2025
Clinical Diagnostics & Research Virtual Event Series 2025
Event Date: November 12, 2025
(Download 2026 Virtual Event Schedule)
Drug Discovery & Development Virtual Event Series 2026
Event Date: February 18, 2026
Neuroscience Virtual Event Series 2026
Event Date: March 4, 2026
Laboratory Automation Virtual Event Series 2026
Event Date: March 18, 2026
Bioprocessing Virtual Event Series 2026
Event Date: April 1, 2026
Cannabis Sciences Virtual Event Series 2026
Event Date: April 15, 2026
Immuno-Oncology Virtual Event Series 2026
Event Date: April 29, 2026
Precision Medicine: Genomics, Genetics & Molecular Diagnostics Virtual Event Series 2026
Event Date: May 13, 2026
Microbiology Virtual Event Series 2026
Event Date: September 2, 2026
Cell Biology Virtual Event Series 2026
Event Date: September 16, 2026
Cancer Research & Oncology Virtual Event Series 2026
Event Date: September 30, 2026
Cell & Gene Therapy Virtual Event Series 2026
Event Date: October 14, 2026
Clinical Diagnostics & Research Virtual Event Series 2026
Event Date: November 11, 2026
Interested in hosting a custom virtual event? Click here to learn more.

CALL FOR POSTERS
SUBMISSION IS FREE.
Posters will be published during the event for which they are submitted and will remain accessible in the virtual environment during the live and on-demand period.
Interested in sponsoring a poster? Click "Request Info" and we will contact you with more information.
Sponsorship & Advertising Opportunities
Become a part of our users' virtual experience. As a sponsor of one or more upcoming Labroots virtual events which stay on our website for users to experience the content on-demand, you're providing ongoing visibility to your company.
How it works:
Choose from one of our many sponsorship placements (see below) and the Labroots team will work closely with you to customize your campaign within the event environment. During the live event, virtual exhibitors and advertisers can interact and distribute information with their target audience directly. After each event, Labroots will provide a detailed report of booth attendees, webinar attendees, or of whichever sponsorship opportunity was chosen.










Placement Options:
- Virtual Booth with logos, images, videos, digital assets, online chat, and customization options
- Sponsor speakers, live webinar presentation via webcam
- Keynote speaker sponsorship, in studio opportunities
- Lobby Greeting
- MPU: 300 x 250 pixels
- Virtual Lab, build a custom laboratory with your products
- Banner ads in the lobby, poster hall, and lounge
- Pre-event newsletter advertising
- Pop-up announcements
- Speed Networking
Extend Your Reach:
Virtual Event Series make it easy and convenient to share content. Virtual exhibitors and advertisers can interact and distribute information with their target audience.
Sponsors Can Engage With Attendees Via:
- Text and Video Chat
- X, Facebook and Linkedin
- Networking Lounge
- Live Q&A
- Speaker Polling
- CE Continuing Education
Virtual Event Series Samples
WAVE Trial Package
Get your feet wet with the Labroots Webinar & Virtual Event (WAVE) Trial Package. The perfect sampling of webinar and Virtual Event Series products, the WAVE Trial Package allows you to explore which Labroots virtual product provides the best ROI for your company and/or campaign.
- 1 Webinar
- 2 Virtual Events (get to choose)
- 2 Virtual Event Booths OR 2 Track Speakers OR 1 Virtual Event Booth & 1 Track Speaker




Want an entire virtual event just to yourself?
Host a custom virtual event with Labroots. We have a variety of case studies compiled here that showcase the Labroots client experience and how we helped them achieve their unique goals. Click the case studies button below to read more, or click here to learn about hosting a custom virtual event with Labroots.
What Do You Get Out of a Virtual Event?
Gauge user interest and behavior, and receive in-depth participant data.
Reporting Features Include:
- Generate hundreds of targeted leads of the people who enter your virtual booth or sponsored webinar, with detailed complete contact information including: Name, Job, Title, Degree Institution, Phone Number, Email Address, and more!
- Detailed Demographics
- Conference Statistics
- Behavioral Data
- Qualify the booth leads by understanding their interests. Every asset click is tracked and noted in a detailed report.
- Grow your e-marketing lists by taking home the entire registration report which can be as high as 20,000 contacts.
- Polling Results
- CE Continuing Education

Explore Our
Editorial
Calendar
Continuing Education Credits
By participating in some of our virtual events and webinars, you can earn Continuing Education credits. Each event offers different educational credits based on the content of the event and the eligibility of the presentation. Please see below for the types of CE’s offered.
Professional Acknowledgment for Continuing Education (P.A.C.E.)
All laboratory professionals who are licensed or certified need continuing education (CE). Some employers also require CE in addition to or in place of those requirements. This includes all Medical Laboratory Scientists, formerly Clinical Laboratory Scientists or Medical Technologists (known as MLSs, CLSs, or MTs); all Medical Laboratory Technicians, formerly Clinical Laboratory Technicians (known as MLTs or CLTs); and some Phlebotomy Technicians or PBTs. Typically, they need 12 contact hours per year to meet most requirements. Labroots is an approved provider of P.A.C.E. CE credits through the ASCLS. P.A.C.E. CE credits are acceptable in all states and countries except for Florida, USA. We are an approved provider of Florida CE’s through the State of Florida CE Broker. P.A.C.E. CE credits are available during the presentations enduring (on-demand) period and expire after one year from the date of the live broadcast.
Continuing Medical Education (CME)
Continuing Medical Education (CME) credits are essential for medical professionals to maintain their licensure and stay updated on the latest advancements in their field. These credits are obtained through educational activities which are developed and reviewed by experts in clinical areas, designed to sustain, develop, and increase the knowledge and skills necessary for optimal patient care. CME is a cornerstone of lifelong learning for healthcare professionals, ensuring that their expertise remains current and effective.
Continuing Professional Development (CPD)
Continuing Professional Development (CPD) credits serve as a quantifiable measure of engagement in professional learning and skill enhancement activities. These credits are accumulated by participating in various educational experiences, ranging from formal courses to informal training sessions, and are essential for professionals to maintain their licensure or membership in certain regulatory bodies. CPD credits demonstrate a commitment to continuous personal and professional growth, ensuring that individuals remain knowledgeable and competent in their respective fields.
Continuing Education Unit (CEU)
Continuing Education Units (CEUs) earned through NSGC-approved educational opportunities will be accepted by the American Board of Genetic Counseling for purposes of Genetic Counselor recertification. Labroots works with the NSGC to provide Category 1 CEUs. The NSGC grants a CEU for all educational programs with content targeted specifically to genetic counselors (10 hours of presentation are equivalent to 1 Category 1 CEU). Following the CEU approved presentation, an attendee will be required to take a quiz of the presentation and pass it (pass no-fail), as well as fill out an evaluation and submit a $25 fee, to receive their CEU certificate. These certificates are processed and provided by the NSGC. A CEU credit is available during the presentation enduring (on-demand) period and expires after 2 years from the date of the live broadcast.
American Association of Veterinary State Boards Registry of Approved Continuing Education (RACE)
Veterinarians must certify that they have completed a certain number of hours of approved continuing education to renew their license to practice veterinary medicine. Typically, they need 36 hours per year to meet requirements. Labroots is a provider of R.A.C.E. through the American Association of Veterinary State Boards (AAVSB). Following the CE-approved presentation, an attendee will be required to fill out an evaluation of the presentation to receive their CE certificate. These certificates are processed and provided by Labroots. R.A.C.E. CE credits are available during the presentations enduring (on-demand) period and expire after one year from the date of the live broadcast.